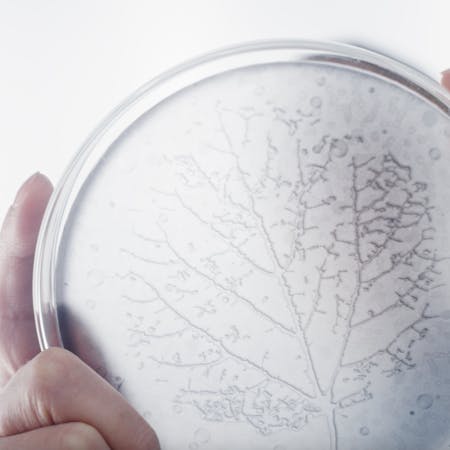

Brightening science
Agency: Zorba Shanghai
BRIGHTENING BOOSTER SERUM SCIENTIFIC STORYTELLING

Exclusive scientific storytelling for the launch of Eucerin's new Brightening Booster Serum in China.
The campaign
On a strong but very challenging skin brightening market, with low differentiation among players, Eucerin was seeking advice on how to stand-out from the crowd. We worked together to spot and highlight what makes the German brand so special and relevant for Chinese audiences: its science.
SCIENCE x DERMA
The challenge
Increase Eucerin's attractiveness and uniqueness on the Chinese market through science, by pointing out a unique and onwable expertise on the brightening topic. Beyond content, we first questioned and precised brand's scientific positioning and territory, which paved the way for compelling creative execution.
The answer
True. Precise. Potent. 3 words at the heart of a creative campaign that takes the audience right into Eucerin's labs. 3 words that perfectly summarize the German style behind research and development, and the undeniable rigor that gave birth to a unique active ingredient and the associated product's performance.
The job
A new derma science storyteling resting on a redefined tone of voice and visual identity. All this brought to life in video and still content supporting the launch of the new Brightening Booster Serum in Asia, more specifically China.

Client : Erno Laszlo
Micro-Essence